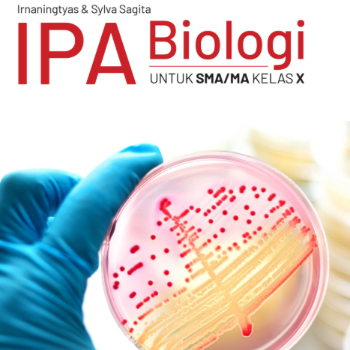
Card image

Harga Rp. 128.000 DPP Nilai Lain Rp. 0 DPP PPh Rp. 128.000 PPN 12% Rp. 0

Harga Rp. 129.000 DPP Nilai Lain Rp. 0 DPP PPh Rp. 129.000 PPN 12% Rp. 0

Harga Rp. 90.000 DPP Nilai Lain Rp. 0 DPP PPh Rp. 90.000 PPN 12% Rp. 0

Harga Rp. 178.000 DPP Nilai Lain Rp. 0 DPP PPh Rp. 178.000 PPN 12% Rp. 0

Harga Rp. 145.000 DPP Nilai Lain Rp. 0 DPP PPh Rp. 145.000 PPN 12% Rp. 0
Harga Rp. 166.000 DPP Nilai Lain Rp. 0 DPP PPh Rp. 166.000 PPN 12% Rp. 0

Harga Rp. 124.000 DPP Nilai Lain Rp. 0 DPP PPh Rp. 124.000 PPN 12% Rp. 0

Harga Rp. 120.000 DPP Nilai Lain Rp. 0 DPP PPh Rp. 120.000 PPN 12% Rp. 0

Harga Rp. 144.000 DPP Nilai Lain Rp. 0 DPP PPh Rp. 144.000 PPN 12% Rp. 0

Harga Rp. 152.000 DPP Nilai Lain Rp. 0 DPP PPh Rp. 152.000 PPN 12% Rp. 0

Harga Rp. 146.000 DPP Nilai Lain Rp. 0 DPP PPh Rp. 146.000 PPN 12% Rp. 0

Harga Rp. 158.000 DPP Nilai Lain Rp. 0 DPP PPh Rp. 158.000 PPN 12% Rp. 0

Harga Rp. 221.000 DPP Nilai Lain Rp. 0 DPP PPh Rp. 221.000 PPN 12% Rp. 0

Harga Rp. 90.000 DPP Nilai Lain Rp. 0 DPP PPh Rp. 90.000 PPN 12% Rp. 0

Harga Rp. 171.000 DPP Nilai Lain Rp. 0 DPP PPh Rp. 171.000 PPN 12% Rp. 0

Harga Rp. 156.000 DPP Nilai Lain Rp. 0 DPP PPh Rp. 156.000 PPN 12% Rp. 0

Harga Rp. 129.000 DPP Nilai Lain Rp. 0 DPP PPh Rp. 129.000 PPN 12% Rp. 0

Harga Rp. 171.000 DPP Nilai Lain Rp. 0 DPP PPh Rp. 171.000 PPN 12% Rp. 0

Harga Rp. 104.000 DPP Nilai Lain Rp. 0 DPP PPh Rp. 104.000 PPN 12% Rp. 0

Harga Rp. 86.000 DPP Nilai Lain Rp. 0 DPP PPh Rp. 86.000 PPN 12% Rp. 0